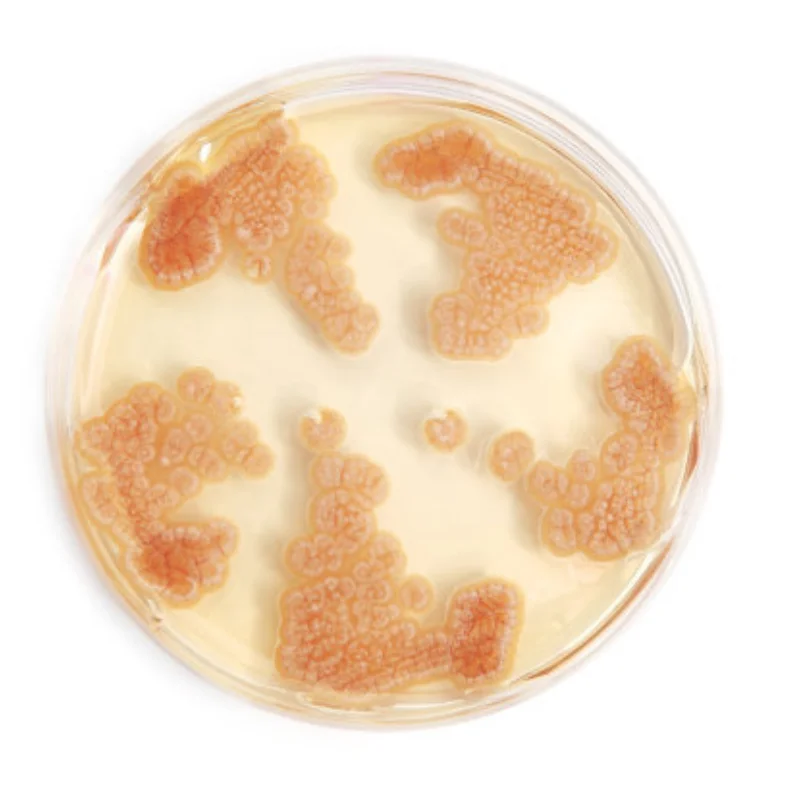
7760 Алюминиевое переднее и заднее крепление двигателя для быстрой разборки деталей радиоуправляемого автомобиля Trxs 6S 8S 1/6 XRT 78086-4 1/5 XMAXX X-maxx Обновление

Зимние меховые перчатки с мехом кролика кота пушистые рукавицы без пальцев женские плюшевые теплые перчатки для девочек мягкие варежки для...













артикул: 1005003642382927
СОГЛАСНО НАШИМ ДАННЫМ, ЭТОТ ПРОДУКТ СЕЙЧАС НЕ ДОСТУПЕН
$5.23
Доставка из: Китай
Характеристики
| commissionRate: | 5.38% |
| discount: | 51% |
Пользователи также просматривали

$15.76
3 D milling machine Three-coordinate precision centering rod tool accuracy 0.01mm 3D edge finder CNC mechanical machining center
aliexpress.com
$10.37
Рюкзаки с узором капибары, вместительная Студенческая сумка для книг, сумка на плечо, рюкзак для ноутбука, водонепроницаемый дорожный рюкзак, школьная сумка
aliexpress.ru
$22.00
Плюшевая хлопковая кукла, Милая лоли с большими глазами для девочек, 20 см, без свойств, сменная одежда, плюшевая подушка для косплея, подарок на день рождения
aliexpress.ru
$0.95
Шлифовальный станок для ног, нанопилка для педикюра и педикюра, средство для ухода за ногами, отшелушивание мозолей и мертвых ног, средство для полировки, G5U2
aliexpress.ru
$7.99
Newborn Baby And Toddler Boys Basic Straight Jeans - Denim - The Children's Place
childrensplace.com
$12.45
Противоскользящий коврик для ванной, сауны, бассейна JOYARTY, Разноцветный (мультиколор), Эйфелева башня волшебна
vseinstrumenti.ru
$49.73
Тени для век Impeccable Compact Eye Shadow Refill Collistar, цвет n.210 champagne satin
cdek.shopping
$29.01
Кремовая футболка с длинными рукавами и цветочным принтом для девочек (для новорожденных – 23 мес.), белый
cdek.shopping
$13.84
Держатель для карниза SEWS-6 шт., универсальный самоклеящийся настенный держатель для карниза, крючки для карниза для ванной комнаты
aliexpress.ru
$2.99
Женский кожаный ремень MYMC, ремень для джинсов для девушек с крутой пряжкой, пояс с отверстиями, универсальный ремень, повседневный стильный ...
aliexpress.ru
$2.45
JHJT 16G Cartilage Earring Stud Nail 316L Surgical Stainless Steel Multicolor Sea Star Shape Ear Stud Piercing Jewelry
aliexpress.com
$70.03
Набор из 4 катушек зажигания для Yamaha Super Tenere XTZ1200 2012-2020 23P-82310-00-00 F6T548
aliexpress.ru
$24.94
Женский рюкзак из искусственной кожи, черный вместительный школьный рюкзак для девочек-подростков из мягкой кожи, для отдыха и путешествий,...
aliexpress.ru
$1.44
2021 New 5D Engraved Nail Art Sticker English Alphabet Letter Number Shaped Ultra-thin Adhesive Slider Nails Decals Decoraciones
aliexpress.ru
$18.41
2011 1190 RC8R RC390 все годы для 200x Полный Комплект болтов обтекателя винтовые клипсы
aliexpress.ru
$12.83
Пара защитных зимних утепленных лыжных перчаток для скалолазания сохраняют тепло для езды на сноуборде водонепроницаемых занятий спортом ...
aliexpress.ru
$12.74
Children's Animal Farm Piano Music Toy eEducational Electronic Organ Baby Playing Instrument Recognition Ability Gifts
aliexpress.ru
$7.71
H7 100 Вт 499 супер белый ксеноновый обновленный Hid автомобильный 477 лампы для фар T10 501 4x 12 В
aliexpress.ru
$8.06
Альбом-кошелек с 96 карманами для фотографий, чехол для Fujifilm Instax Leica Mini LOMO Sofort, отличный подарок для детей и друзей, 3 дюйма
aliexpress.ru
$7.28
Мужская футболка с коротким рукавом, черная свободная футболка Rockin 2022, новинка на лето 1000
aliexpress.ru
$5.97
Держатель для зубной щетки с присоской, настенные крючки, многоразовый крючок-присоска без дрели для кухни, ванной комнаты, дома
aliexpress.ru
$15.49
Подставка для телефона iPhone 12 Pro 11 Xiaomi, алюминиевый держатель для телефона, подставка для планшетов, держатель для сотового телефона Huawei, Samsung
aliexpress.ru
$2,394.00
Cartier Amulette de Cartier Diamond Onyx Mother of Pearl 18K Rose Gold Necklace
theluxurycloset.com
$61.35
women's jackets caju flower return letter embrodiery retro lapel vibe jeans of men washed harajuku jackets torn jacket oversize denim c, Black;brown
dhgate.com
$24.85
detroitpistonsmen luke kennard blake griffin derrick rose andre drummond black custom golden edition jersey
dhgate.com
$14.64
Фреза обгонная с нижним подшипником (12.7x31.8 мм; z=2; s=12 мм) arden 151241
vseinstrumenti.ru
$110.00
Piston kit 82mm NC250 Zongshen177 NC300 Big Bore zs 177 engine tuning racing nc250 300 set zongshen motocross of-road
aliexpress.com